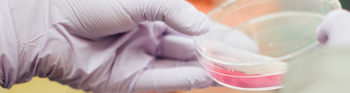
наука

Рейтинг сайтов компаний
Рейтинг сайтов - это числовая оценка, которая отражает степень популярности, значимости или качества конкретного веб-сайта.
Рейтинги сайтов имеют важное значение в Интернете, поскольку они помогают пользователям определить, насколько надежным, авторитетным или интересным может быть данный веб-ресурс.
Существует несколько способов определения рейтинга сайтов. Один из самых распространенных методов - использование алгоритмов, сервисов определения параметров качества и систем рейтинга, таких как Alexa Rank, Google PageRank и Catalog Tools и многих других что есть в сети.
Catalog Tools использует метод рейтинга на основе оценок сайта пользователями. Catalog Tools присваивает каждому сайту уникальный номер, который указывает его позицию относительно других в каталоге сайтов.
Этот рейтинг используется для определения релевантности и веса страницы при поисковых запросах пользователей.
Веб-сайты, предоставляющие услуги или продукты, часто позволяют пользователям оставлять отзывы о своем опыте и ставить оценки. Эти оценки затем могут быть использованы для вычисления рейтинга сайта.
Это особенно популярно в сфере электронной коммерции, где рейтинги и отзывы пользователей могут повлиять на решение покупателей. Важно отметить, что рейтинг сайтов не всегда является объективной мерой качества или надежности.
В целом, рейтинг сайтов предоставляет пользователю некоторую ориентацию и помогает принимать решения о выборе веб-ресурса. Однако важно учитывать и другие факторы, такие как содержание, дизайн и удобство использования сайта, а не полагаться исключительно на рейтинг при оценке его качества.
Список сайтов и компаний
Список сайтов (каталог сайтов) компаний - фирмы и сайты с рейтингом и отзывами, справочник организаций предоставляющие качественные услуги, сайт в котором собраны данные о услугах, товарах, компаниях, ИП.
Можно оставить заявку на добавление организации в каталог - после модерации Ваша информация будет добавлена и примет участие в рейтинге сайтов.
Данный список сайтов (каталог сайтов) представляет собой структурированную базу различных предприятий, сайтов, товаров, услуг, организаций по России, СНГ и всему миру.
Каталог сайтов содержит в себе информацию о юридических лицах и частных предпринимателей:
- фактический и юридический адрес
- основная сфера деятельности
- контактные данные
- отзывы клиентов
- сайт
- данные из государственных реестров (если данные были указаны владельцем)
Бизнес справочник с рейтингом и отзывами
Количество реально действующих компаний и сайтов достигает количества в несколько десятков тысяч зарегистрированных юридических лиц.
Встроенная поисковая система бизнес каталога позволяет быстро найти нужную компанию или сайт по ее названию, сайту или регистрационному номеру.
Наибольшую роль в достоверность и актуальности информации, которая содержится в в каталоге сайтов, имеет количество внесенных сведений и характер их внесения.
Количество организаций, внесенных в каталог, постоянно растет. Каталог специализируется на различные бизнес сферы деятельности и может содержать сведения, которые участники добавляют на страницах данных объектов. Список сайтов фирм является обще-тематическим, главное преимущество — актуальность предоставляемой информации от владельцев предприятий, поскольку каждый владелец добавляет нужное описание деятельности его проекта.
Добавление сайта в каталог Catalog tools является положительным фактором для поисковых систем (Яндекс и Google и других), а именно это дополнительные переходы на ресурсы, индексация отдельных страниц компаний, оставление отзывов, оценка сайтов пользователями портала Catalog tools.
Недавно добавленные сайты в каталог сайтов
Дата добавления - 07.04.2026 Прочитавших: 54 | | |

Дата добавления - 07.04.2026 Прочитавших: 28 | | |

Дата добавления - 02.04.2026 Прочитавших: 24 | | |

Дата добавления - 02.04.2026 Прочитавших: 27 | | |

Дата добавления - 29.03.2026 Прочитавших: 34 | | |

Дата добавления - 29.03.2026 Прочитавших: 34 | | |

Заповедник - интернет-магазин для домашних животных Зоомагазины, товары для питомцевРейтинг сайта - 5.0 Дата добавления - 29.03.2026 Прочитавших: 45 | | |

Дата добавления - 26.03.2026 Прочитавших: 31 | | |

Дата добавления - 13.03.2026 Прочитавших: 92 | | |

Дата добавления - 08.01.2026 Прочитавших: 133 | | |